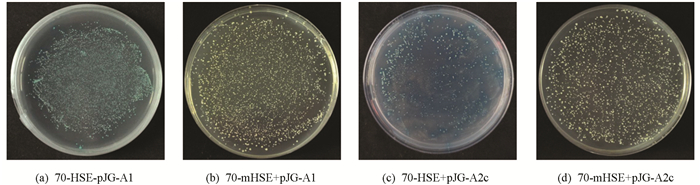

-
开放科学(资源服务)标志码(OSID):

-
植物热激蛋白(Heat shock proteins,HSPs)又称为热休克蛋白,最早在地中海果蝇中发现[1],是哺乳动物和植物中广泛存在的一类保守蛋白质. 热激蛋白在生物体对外界各种生物或非生物胁迫作出应答反应时作为分子伴侣发挥着关键作用[2-4]. 按照蛋白分子量的不同,热休克蛋白共分为5类,即HSP100,HSP90,HSP70,HSP60以及小分子热休克蛋白sHSP. 其中,HSP70作为热激蛋白家族的重要成员之一,其典型结构包括高度保守的N端44 kDa的核苷酸结合结构域(nucleo-tide binding domain,NBD)和C端18 kDa的底物结合结构域(substrate binding domain,SBD),以及铰链(linker)结构[5-6].
研究表明,HSP70在植物中主要参与细胞内蛋白质的合成、折叠、运输和降解修复等过程[7-8],它在细胞内大量表达可以显著改善细胞的生存能力,进而明显提高植物抵御各种环境胁迫的耐受能力. 如在拟南芥中,过表达HSP70基因可以增强拟南芥植株的耐热性,且经过热处理后,转基因幼苗对渗透、盐和氧化胁迫的耐受性比野生型更强[9]. Song等[10]将菊花CgHSP70基因转入拟南芥中可以提高转基因植株对干旱以及高盐的耐受能力. Batcho等[11]将龙舌兰AsHSP70基因转入棉花中可以提高陆地棉耐热性,可用于棉花热胁迫改良育种. 在甘蓝型油菜中超表达BnA7HSP70基因能够提高植株对干旱条件的耐受性[12]. 芍药PlHSP70基因在拟南芥中进行超表达,在热胁迫下转基因比野生型拟南芥的耐高温能力更强,植株生长更好[13]. 在高温胁迫下,热激蛋白的表达均受到热激转录因子(Heat shock transcription factors,HSFs)的调控,HSFs与热激蛋白启动子区HSEs(5′-AGAAnnTTCT-3′)元件结合,促进热激蛋白的表达[14-16]. 南瓜HSP70基因启动子中含有多个信号元件,说明南瓜HSP70基因可能参与多种功能的调控[17]. 利用荧光素酶(LUC)报告基因对转基因水稻OsHSP16.9C启动子进行缺失分析,发现含有不完全热激元件(HSE)的启动子片段在热诱导中起关键作用[18]. 魔芋含有大量的葡甘露聚糖(Konjac glucomannan,KGM),具有很高的营养和经济价值,喜冷凉不耐高温[19]. 目前对于魔芋的分子研究较少,多为生理方面的研究,比如低温诱导对白魔芋产生多叶,开花过程中内源激素变化,层积处理打破实生种子休眠以及魔芋软腐病拮抗放线菌的筛选等[20-23]. 本课题组已在前期的研究中同源克隆出白魔芋AaHSP70基因,并对其进行了生物信息学分析,NCBI(https://www.ncbi.nlm.nih.gov/)在线预测显示在AaHSP70蛋白N端9-387氨基酸是一个HSP70特有的核苷酸结构域NBD,并发现其与野生稻(Oryza brachyantha,XM_006664054)的同源性最高[24].
然而HSP70是否对魔芋抵御热胁迫有促进作用,其启动子是怎样参与热胁迫调控还尚不清楚. 因此,基于之前研究,从白魔芋中克隆AaHSP70的CDS和启动子序列,对其进行表达模式分析,以及酵母单杂交和双荧光素酶试验,并构建该prAaHSP70-GUS融合表达载体转化拟南芥. 此研究探讨了HSP70启动子在魔芋耐热过程中的调控作用,为魔芋的耐热品种选育提供理论基础.
全文HTML
-
试验于2019年3月-2020年10月在西南大学魔芋研究中心进行,供试材料为白魔芋(Amorphophallus albus),展叶时移至光照培养箱,25 ℃预培养2 d后进行41 ℃高温处理. 分别在处理0,0.5,1,2,4,8,12和24 h后取植株叶片、幼嫩新根和球茎,液氮速冻后-80 ℃保存备用. 上述组织及处理均重复3次. 哥伦比亚野生型拟南芥株系(Columbia,Col-0)用于GUS染色. 本氏烟草(Nicotiana benthamiana)用来进行双荧光素酶试验. 基因克隆所用大肠杆菌(Escheriachia coli)T1感受态细胞购于Beijing Transgen Biotech公司,农杆菌感受态GV3101和GV3101(pSoup)均购于上海唯地生物技术有限公司,PCR引物合成和DNA序列测定由北京六合华大基因科技有限公司完成.
-
白魔芋、拟南芥叶片基因组DNA以及白魔芋各组织总RNA提取,参照北京华越洋新型植物DNA,RNA提取试剂盒(Cat.No:0419-50,CB型)说明书操作. 采用PrimeScriptTM RT reagent Kit(TaKaRa)进行反转录合成cDNA,-20 ℃保存备用.
-
基于实验室前期研究结果以及同源克隆,利用Primer 3 Plus设计两条特异引物HSP70-F和HSP70-R(表 1),获得AaHSP70基因序列. PCR产物用1%的琼脂糖凝胶和DNA凝胶回收试剂盒进行分离纯化. 将PCR产物连接克隆载体pEASY-Blunt Simple Cloning Vector并转化大肠杆菌T1感受态细胞,获得阳性克隆.
根据白魔芋AaHSP70的DNA序列设计特异性引物HSP70-SP1,HSP70-SP2,HSP70-SP3,利用FPNI-PCR法通过3轮步移扩增AaHSP70启动子[25]. 以白魔芋的基因组DNA为模板,设计HSP70启动子的引物prHSP70-F,prHSP70-R(表 1),克隆HSP70启动子区1 062 bp的序列.
利用在线软件Plant Care(http://bioinformatics.psb.ugent.be/webtools/plantcare/html/)预测启动子序列中的结构基序和调节元件.
-
根据AaHSP70的ORF序列,利用Primer 5.0设计qRT-PCR引物HSP70-RT-F和HSP70-RT-R. 以白魔芋展叶期3个器官(叶、根、茎)在热处理不同时间下的cDNA为模板,以EIF4A为内参基因[26],引物见表 1. 用SYBR Green荧光染料,在Bio-Rad CFX96荧光定量PCR仪上进行目标基因表达水平的检测. 参照SsoFast EvaGreen Supermix试剂说明书设置PCR反应程序. 设置3次重复,比较CT法(2-ΔΔCt法)[27]计算相对表达量.
-
分析AaHSP70启动子序列,根据HSE元件及AaHSFA1,AaHSFA2c基因的ORF序列以及酵母单杂交载体pLacZi和pJG4-5上的酶切位点特征设计引物. 将prHSP70-HSE和prHSP70-mHSE(对照)的F/R引物各吸取10 μL进行PCR反应,反应体系为95 ℃ 10 min,72 ℃ 5 min,23 ℃ 30 s,4 ℃保存,然后对PCR产物进行纯化. 将已纯化的PCR产物分别与pLacZi空载质粒用Eco RⅠ和Xho Ⅰ进行酶切后进行连接. 测序引物为pLacZi-F,pLacZi-R(表 1). 将构建成功的pJG4-5-HSFA1,pJG4-5-HSFA2c质粒分别和prHSP70-HSE,prHSP70-mHSE共转至EGY48酵母感受态细胞中,选择阳性菌落涂布于SD/-Ura/-Trp/X-gal显色平板,28~30 ℃培养3~5 d后观察显色反应. 酵母单杂交试剂均购于北京酷来搏科技有限公司.
-
将AaHSP70的启动子序列构建到pGreenⅡ0800-LUC载体上作为报告基因,将AaHSFA1和AaHSFA2c基因全长重组到pGreenⅡ62-SK载体上作为效应基因,引物序列见表 1. 将所构的双荧光素酶重组质粒转入农杆菌感受态GV3101(pSoup)上,然后再将pGreenⅡ0800-LUC-prHSP70和pGreenⅡ62-SK-HSFA1,pGreenⅡ62-SK-HSFA2c的农杆菌菌液按相同OD600值1∶9的体积比混合;将菌液pGreenⅡ0800-LUC-prHSP70与菌液pGreenⅡ62-SK按相同方法进行混合并作为阴性对照. 注射烟草叶背面培养48~72 h后在GloMax©-Multi+多功能酶标仪上测定萤火虫荧光素酶(LUC)与海肾荧光素酶(REN)的活性值,并计算萤火虫荧光素酶与海肾荧光素酶的比值来反映转录活性.
-
根据农杆菌GV3101介导的花粉管侵染法[28]将启动子用重组质粒prAaHSP70-GUS转化野生型拟南芥. 将T1代拟南芥种子消毒后播种在MS培养基(含50 mg/L卡那霉素)中,初步筛选出绿色抗性苗,并移入土中培养. 提取T1代抗性幼苗的DNA[29],用引物(表 1)鉴定阳性转基因植株,用相同方法筛选至获得T3代纯合子转基因植株.
-
将获得的T3代转基因拟南芥植株幼苗在39 ℃高温下处理2 h,根据华越洋GUS染色试剂盒进行组织染色,用70%乙醇浸泡至完全脱色后在体式显微镜下观察拍照. 以野生型拟南芥为阴性对照,转pBI121空载的拟南芥为阳性对照.
1.1. 试验材料与处理
1.2. DNA,RNA的提取与cDNA的合成
1.3. CDS和启动子序列克隆及生物信息学分析
1.4. AaHSP70的荧光定量分析
1.5. 酵母单杂交试验
1.6. 双荧光素酶试验
1.7. prAaHSP70转化拟南芥
1.8. GUS组织化学染色
-
荧光定量结果表明(图 1),白魔芋AaHSP70基因对热胁迫较敏感. 在热处理1 h时,叶、根、茎中的表达量都达到峰值,且在叶片中的表达量最高,说明在1 h时其表达丰度最高. 经过8 h热处理后,AaHSP70基因的表达量相对较低. 与对照相比,不同热处理时间都可以不同程度地调控AaHSP70基因的表达. 此外,将3个组织的表达量进行比较,发现叶片中的相对表达量最高.
-
以白魔芋gDNA为模板,利用FPNI-PCR法3轮扩增后,在1 000 bp左右出现特异性条带(图 2). 通过胶回收,连接转化并测序得到1 062 bp的AaHSP70启动子区域. 利用Plant Care在线分析AaHSP70启动子的顺式作用元件,结果发现该启动子含有多个TATA-box和CAAT-box启动子的基本核心元件,此外,含有热胁迫响应元件(Heat Shock Response Element,HSE),脱落酸、茉莉酸调控应答元件,多种光应答元件等(图 3和表 2).
-
为分析AaHSP70的作用模式,利用酵母单杂交和双荧光素酶系统检测AaHSFA1,AaHSFA2c与AaHSP70启动子的互作. 酵母单杂交结果表明,AaHSFA1,AaHSFA2c与AaHSP70启动子HSE元件有互作,但与对照mHSE无互作(图 4). 双荧光素酶试验结果进一步表明,AaHSFA1,AaHSFA2c与AaHSP70启动子有相互作用(图 5).
-
提取T3代纯合转基因拟南芥叶片DNA,以引物prHSP70-F,prHSP70-R进行PCR检测,成功获得了转prAaHSP70-GUS拟南芥纯合材料5株(图 6). 检测转prAaHSP70-GUS T3代拟南芥阳性植株GUS基因的表达情况(图 7),结果显示,转入空载pBI121的拟南芥阳性幼苗整个植株都呈蓝色,野生型拟南芥植株无蓝色斑点,未经处理的转prAaHSP70-GUS拟南芥阳性植株在根上出现少量蓝色斑点,经过高温处理后整株都呈现蓝色,说明prAaHSP70属于高温诱导型启动子.
2.1. AaHSP70的不同组织表达热处理后模式分析
2.2. AaHSP70启动子的克隆和序列分析
2.3. AaHSFA1,AaHSFA2c与AaHSP70启动子有相互作用
2.4. prAaHSP70-GUS拟南芥的获得及组织化学染色分析
-
本研究是在实验室前期研究的基础上,从白魔芋中克隆得到了AaHSP70基因CDS和启动子序列,对其启动子序列特征进行了分析,在拟南芥中对AaHSP70进行了初步的功能验证,并对AaHSP70在白魔芋中的时空表达以及其启动子的转录活性进行了初步探索.
植物HSPs在不同组织中具有不同的表达模式,Guo等[30]研究发现辣椒CaHSP70-1基因40 ℃处理2 h后,在叶和花中的相对表达量最高. 玉米在42 ℃处理2 h后,ZmHSP70基因的表达量达到最大值[31]. 高温条件下,中国南瓜成熟叶片中的3个CmHSP70基因均能够在短时间内(0~2 h)大量表达[32]. 高温胁迫能够诱导叶用莴苣LsHSP70基因的表达[33]. 本研究中,白魔芋AaHSP70在41 ℃高温处理1 h后叶、根、茎中的相对表达量都迅速达到最大值,但在叶片中的表达量显著高于根和茎,说明AaHSP70表达具有组织特异性.
目前报道的启动子主要分为3大类:组成型、组织特异型和诱导型启动子[34-35]. 已有研究表明,HSFA1,HSFA2可以调控HSP蛋白的表达[36-37]. 在本试验中,我们通过酵母单杂交和双荧光素酶试验发现,AaHSFA1和AaHSFA2c蛋白可以与AaHSP70启动子发生相互作用,表明AaHSFA1和AaHSFA2c参与调控AaHSP70,但具体调控通路有待进一步验证. 转基因拟南芥经过GUS化学染色后,组织表达模式分析结果显示,热处理前prAaHSP70-GUS在根部表达,而热处理后整株拟南芥均表达,说明AaHSP70启动子是一个能响应高温胁迫的诱导型启动子. 热处理后,AaHSP70启动子活性明显增强,对比定量结果(图 1),可以看出白魔芋HSP70表达模式与其启动子活性分析结果一致.
前人研究发现水稻OsHSP70家族基因启动子中富集了HSE,ABRE,DRE等顺式元件,这些元件与胁迫、激素调控有关[38]. 将豌豆PsHSP70基因启动子与GUS报告子融合的嵌合基因导入烟草中,该嵌合基因在成熟植物的茎和根的韧皮部特异性表达以应对热激[39]. 启动子分析表明,酸枣ZjHSP70和ZjHSP100启动子中均具有与非生物胁迫相关的多种功能[40]. 魔芋AaHSP70启动子中含有多个启动子基本的核心元件CAAT-box和TATA-box,在该序列中,还包含特定的调控元件,如与热胁迫相关的HSE元件,与光反应相关的G-box,CGTA-motif,SP1元件,与激素相关的ABRE,TGACG-motif,CGTCA-motif元件等. 本研究推测AaHSP70基因及其启动子可能参与了植株抵御外界胁迫,至于其如何调控热胁迫有待进一步研究.




 下载:
下载: